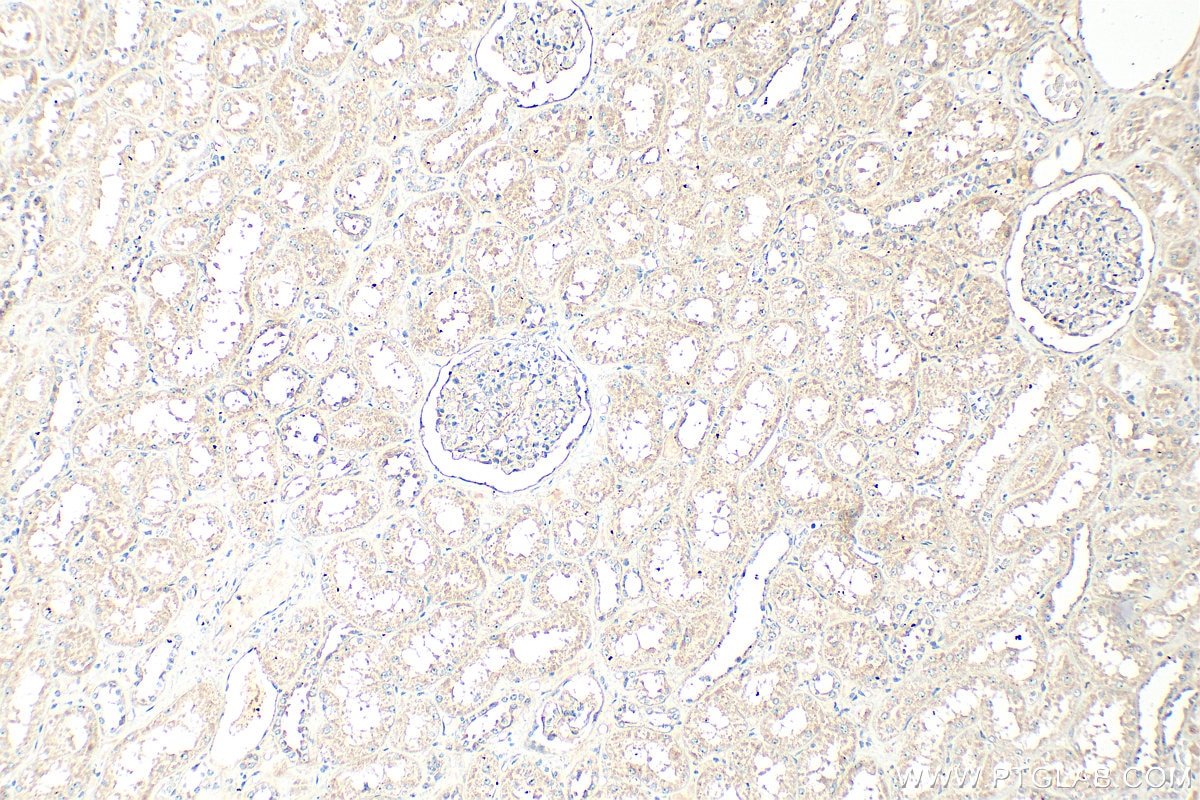
Immunohistochemistry (IHC) staining of human kidney tissue using MGAT4A Polyclonal antibody (25109-1-AP)

Validation Data Gallery
Tested Applications
| Positive WB detected in | HeLa cells, Jurkat cells, THP-1 cells |
| Positive IHC detected in | mouse small intestine tissue, human breast cancer tissue, human kidney tissue Note: suggested antigen retrieval with TE buffer pH 9.0; (*) Alternatively, antigen retrieval may be performed with citrate buffer pH 6.0 |
Recommended dilution
| Application | Dilution |
|---|---|
| Western Blot (WB) | WB : 1:500-1:2000 |
| Immunohistochemistry (IHC) | IHC : 1:50-1:500 |
| It is recommended that this reagent should be titrated in each testing system to obtain optimal results. | |
| Sample-dependent, Check data in validation data gallery. | |
Published Applications
| WB | See 2 publications below |
| IHC | See 2 publications below |
Product Information
25109-1-AP targets MGAT4A in WB, IHC, ELISA applications and shows reactivity with human samples.
| Tested Reactivity | human |
| Cited Reactivity | human, mouse |
| Host / Isotype | Rabbit / IgG |
| Class | Polyclonal |
| Type | Antibody |
| Immunogen |
CatNo: Ag18956 Product name: Recombinant human MGAT4A protein Source: e coli.-derived, PGEX-4T Tag: GST Domain: 395-505 aa of BC127107 Sequence: EVSTSLKVYQGHTLEKTYMGEDFFWAITPIAGDYILFKFDKPVNVESYLFHSGNQEHPGDILLNTTVEVLPFKSEGLEISKETKDKRLEDGYFRIGKFENGVAEGMVDPSL 相同性解析による交差性が予測される生物種 |
| Full Name | mannosyl (alpha-1,3-)-glycoprotein beta-1,4-N-acetylglucosaminyltransferase, isozyme A |
| Calculated molecular weight | 535 aa, 62 kDa |
| Observed molecular weight | 68 kDa |
| GenBank accession number | BC127107 |
| Gene Symbol | MGAT4A |
| Gene ID (NCBI) | 11320 |
| RRID | AB_2879901 |
| Conjugate | Unconjugated |
| Form | |
| Form | Liquid |
| Purification Method | Antigen affinity purification |
| UNIPROT ID | Q9UM21 |
| Storage Buffer | PBS with 0.02% sodium azide and 50% glycerol{{ptg:BufferTemp}}7.3 |
| Storage Conditions | Store at -20°C. Stable for one year after shipment. Aliquoting is unnecessary for -20oC storage. |
Background Information
MGAT4A (alpha-1,3-mannosylglycoprotein 4-beta-N-acetylglucosaminyltransferase A) is a key enzyme that catalyzes the formation of a specific branch on N-linked glycans (the transfer of β1,4-GlcNAc to the α1,3-mannose arm), belonging to the glycosyltransferase family. It is responsible for trimming and remodeling N-glycans in the Golgi apparatus to generate tissue- and disease-specific N-glycan structures. MGAT4A and MGAT4B are isoenzymes that catalyze the transfer of GlcNAc via a β1-4 linkage to the α1-3 linked mannose of the N-glycan core, thereby regulating glycoprotein maturation and function. This enzyme is involved in immunoglobulin G glycosylation, insulin receptor signaling, and neural cell adhesion molecule function. Deficiency of MGAT4A leads to decreased IgG galactosylation and enhanced pro-inflammatory activity, which is associated with an increased risk of autoimmune diseases such as rheumatoid arthritis and IgA nephropathy. Concurrently, it affects insulin secretion in pancreatic β-cells, highlighting its dual role in metabolic regulation and immune homeostasis.
Protocols
| Product Specific Protocols | |
|---|---|
| IHC protocol for MGAT4A antibody 25109-1-AP | Download protocol |
| WB protocol for MGAT4A antibody 25109-1-AP | Download protocol |
| Standard Protocols | |
|---|---|
| Click here to view our Standard Protocols |
Publications
| Species | Application | Title |
|---|---|---|
iScience Self-regulation of MGAT4A and MGAT4B activity toward glycoproteins through interaction of lectin domain with their own N-glycans | ||
Biochem Biophys Rep Development and validation of a glycosyltransferase-associated prognostic model for melanoma and characterization of the tumor immune microenvironment using single-cell sequencing data. | ||
Biochim Biophys Acta Mol Cell Res N-glycosylation by N-acetylglucosaminyltransferase IVa enhances the interaction of integrin β1 with vimentin and promotes hepatocellular carcinoma cell motility |